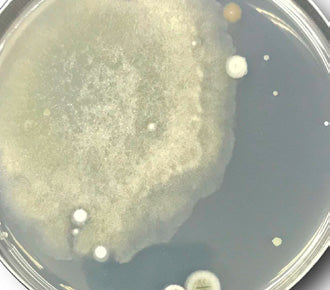

Dr. Esthé Europe
AC Solution Swab
AC Solution Swab
Antibakteriális + Gyulladáscsökkentő + Faggyúszabályozó oldat akné kezelésére
Kiszerelés: 1 ml × 100 db (egyedi tasakos kiszerelés)
Nem sikerült betölteni az átvehetőségi adatokat
20 raktáron
Minden részlet megtekintése



Az AC Solution Swab egy professzionális, klinikai minőségű bőrkezelő megoldás, amelyet kifejezetten aknéra hajlamos, problémás bőr célzott ápolására fejlesztettek. Koreában az első olyan AC-kezelésként vált népszerűvé, amely praktikus, higiénikus, egyesével csomagolt „swab” formátumban érkezik, így bárhol és bármikor azonnali és pontos alkalmazást tesz lehetővé. Több mint 500 000 eladott egységgel bizonyította hatékonyságát és biztonságát, valamint sikeresen teljesítette a „non-comedogenic” tesztet, amely igazolja, hogy nem tömíti el a pórusokat.
Az AC Solution Swab elhozza a gyors, célzott és látható javulást: csökkenti a gyulladást, fertőtleníti a bőrt, szabályozza a faggyútermelést, enyhíti a pirosságot és segít megelőzni az újabb aknék kialakulását. Ideális választás mindennapi használatra, klinikai kezelések kiegészítésére vagy SOS megoldásként problémás területekre.
Kulcs hatóanyagok és hatásaik
Ethanol & Isopropyl Alcohol
- Hatékony antibakteriális és gyulladáscsökkentő kombináció
- Segít fertőtleníteni a bőrfelszínt és megelőzni az újabb gyulladásokat
- Csökkenti a dermális irritációt és szabályozza a túlzott faggyútermelést
*6 aranyló kombináció pattanáscsökkentő és nyugtató összetevőkből

Phytosphingosine
- Erős antibakteriális és gyulladáscsökkentő hatás
- Erősíti a bőr védőrétegét
- Segít helyreállítani a bőr mikroflóráját
Houttuynia Cordata (hallevelűfű kivonat)
- Kiváló nyugtató hatás
- Csökkenti a bőrpírt és a gyulladást,enyhíti a pattanásokat
- Segít eltávolítani a szennyeződéseket a bőrről

Saururus Chinensis kivonat
- Erős antioxidáns,védi a bőrt a stressztől
- Csökkenti a nagyobb pórusok láthatóságát
- Fenntartja a bőr simaságát és egészségét
Saururus Chinensis kivonat
- Erős antioxidáns,védi a bőrt a stressztől
- Csökkenti a nagyobb pórusok láthatóságát
- Fenntartja a bőr simaságát és egészségét
Persimmon Leaf Extract (datolyaszilva-levél kivonat)
- Kondicionálja a bőrt
- Megtisztítja az eltömődött területeket
- Energizálja és üdévé teszi a bőrt
Lavender Extract
- Nyugtatja a bőrt
- Csökkenti az irritációt
- Segít megakadályozni a káros anyagok aktiválódását a bőrbenSaururus Chinensis kivonatErős antioxidáns,védi a bőrt a
stressztől Csökkenti a nagyobb
pórusok láthatóságát
Fenntartja a bőr simaságát és egészségét
Használati utasítás
Arctisztítás után vigye fel közvetlenül az érintett területekre, majd finoman törölje
át a bőrt. Kerülje a szem és a száj környékét. Segít eltávolítani az elhalt hámsejteket, csökkenteni a faggyút és megnyugtatni a bőrt.
Használja reggel és este, vagy szükség esetén akár napközben is célzottan problémás területekre.



